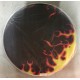
Parche Bombo Llamas 22"

Panier
Aucun produit
À définir Livraison
0,00 € Total
Produit ajouté au panier avec succès
Quantité
Total
Il y a 0 produits dans votre panier. Il y a 1 produit dans votre panier.
Total produits
Frais de port À définir
Total TTC